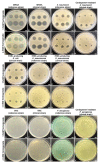

The Antibacterial Activity of Human Amniotic Membrane against Multidrug-Resistant Bacteria Associated with Urinary Tract Infections: New Insights from Normal and Cancerous Urothelial Models
- PMID: 33672670
- PMCID: PMC7924402
- DOI: 10.3390/biomedicines9020218
The Antibacterial Activity of Human Amniotic Membrane against Multidrug-Resistant Bacteria Associated with Urinary Tract Infections: New Insights from Normal and Cancerous Urothelial Models
Abstract
Urinary tract infections (UTIs) represent a serious global health issue, especially due to emerging multidrug-resistant UTI-causing bacteria. Recently, we showed that the human amniotic membrane (hAM) could be a candidate for treatments and prevention of UPEC and Staphylococcus aureus infections. However, its role against multidrug-resistant bacteria, namely methicillin-resistant S. aureus (MRSA), extended-spectrum beta-lactamases (ESBL) producing Escherichia coli and Klebsiella pneumoniae, vancomycin-resistant Enterococci (VRE), carbapenem-resistant Acinetobacter baumannii, and Pseudomonas aeruginosa has not yet been thoroughly explored. Here, we demonstrate for the first time that the hAM homogenate had antibacterial activity against 7 out of 11 tested multidrug-resistant strains, the greatest effect was on MRSA. Using novel approaches, its activity against MRSA was further evaluated in a complex microenvironment of normal and cancerous urinary bladder urothelia. Even short-term incubation in hAM homogenate significantly decreased the number of bacteria in MRSA-infected urothelial models, while it did not affect the viability, number, and ultrastructure of urothelial cells. The hAM patches had no antibacterial activity against any of the tested strains, which further exposes the importance of the hAM preparation. Our study substantially contributes to basic knowledge on the antibacterial activity of hAM and reveals its potential to be used as an antibacterial agent against multidrug-resistant bacteria.
Keywords: MRSA; amniotic membrane homogenate; antibiotic resistance; antimicrobial activity; electron microscopy; multidrug-resistant bacteria; urinary bladder; urothelial cells.
Conflict of interest statement
The authors declare no conflict of interest.
Figures

Similar articles
-
Platelet-rich plasma as an additional therapeutic option for infected wounds with multi-drug resistant bacteria: in vitro antibacterial activity study.Eur J Trauma Emerg Surg. 2019 Jun;45(3):555-565. doi: 10.1007/s00068-018-0957-0. Epub 2018 Apr 26. Eur J Trauma Emerg Surg. 2019. PMID: 29700554
-
Patterns of Drug-Resistant Bacteria in a General Hospital, China, 2011-2016.Pol J Microbiol. 2019;68(2):225-232. doi: 10.33073/pjm-2019-024. Pol J Microbiol. 2019. PMID: 31250593 Free PMC article.
-
Terminalia bellirica fruit extracts: in-vitro antibacterial activity against selected multidrug-resistant bacteria, radical scavenging activity and cytotoxicity study on BHK-21 cells.BMC Complement Altern Med. 2018 Dec 7;18(1):325. doi: 10.1186/s12906-018-2382-7. BMC Complement Altern Med. 2018. PMID: 30526562 Free PMC article.
-
[Fosfomycin--its significance for treatment of diseases due to multidrug-resistant bacteria].Med Monatsschr Pharm. 2015 Jan;38(1):4-11. Med Monatsschr Pharm. 2015. PMID: 26349119 Review. German.
-
High burden of antimicrobial drug resistance in Asia.J Glob Antimicrob Resist. 2014 Sep;2(3):141-147. doi: 10.1016/j.jgar.2014.02.007. Epub 2014 Mar 28. J Glob Antimicrob Resist. 2014. PMID: 27873720 Review.
Cited by
-
A Biomimetic Porcine Urothelial Model for Assessing Escherichia coli Pathogenicity.Microorganisms. 2022 Apr 7;10(4):783. doi: 10.3390/microorganisms10040783. Microorganisms. 2022. PMID: 35456833 Free PMC article.
-
Decellularization of Wharton's Jelly Increases Its Bioactivity and Antibacterial Properties.Front Bioeng Biotechnol. 2022 Mar 11;10:828424. doi: 10.3389/fbioe.2022.828424. eCollection 2022. Front Bioeng Biotechnol. 2022. PMID: 35360386 Free PMC article.
-
Antimicrobial Activity of Human Fetal Membranes: From Biological Function to Clinical Use.Front Bioeng Biotechnol. 2021 May 31;9:691522. doi: 10.3389/fbioe.2021.691522. eCollection 2021. Front Bioeng Biotechnol. 2021. PMID: 34136474 Free PMC article. Review.
-
Dehydrated Human Amnion-Chorion Membrane as a Bioactive Scaffold for Dental Pulp Tissue Regeneration.Biomimetics (Basel). 2024 Dec 18;9(12):771. doi: 10.3390/biomimetics9120771. Biomimetics (Basel). 2024. PMID: 39727775 Free PMC article. Review.
-
Biological importance of human amniotic membrane in tissue engineering and regenerative medicine.Mater Today Bio. 2023 Sep 1;22:100790. doi: 10.1016/j.mtbio.2023.100790. eCollection 2023 Oct. Mater Today Bio. 2023. PMID: 37711653 Free PMC article. Review.
References
-
- Ny S., Edquist P., Dumpis U., Gröndahl-Yli-Hannuksela K., Hermes J., Kling A.M., Klingeberg A., Kozlov R., Källman O., Lis D.O., et al. Antimicrobial resistance of Escherichia coli isolates from outpatient urinary tract infections in women in six European countries including Russia. J. Glob. Antimicrob. Resist. 2019;17:25–34. doi: 10.1016/j.jgar.2018.11.004. - DOI - PubMed
-
- van Driel A.A., Notermans D.W., Meima A., Mulder M., Donker G.A., Stobberingh E.E., Verbon A. Antibiotic resistance of Escherichia coli isolated from uncomplicated UTI in general practice patients over a 10-year period. Eur. J. Clin. Microbiol. Infect. Dis. 2019;38:2151–2158. doi: 10.1007/s10096-019-03655-3. - DOI - PMC - PubMed
Grants and funding
LinkOut - more resources
Full Text Sources
Other Literature Sources
Molecular Biology Databases